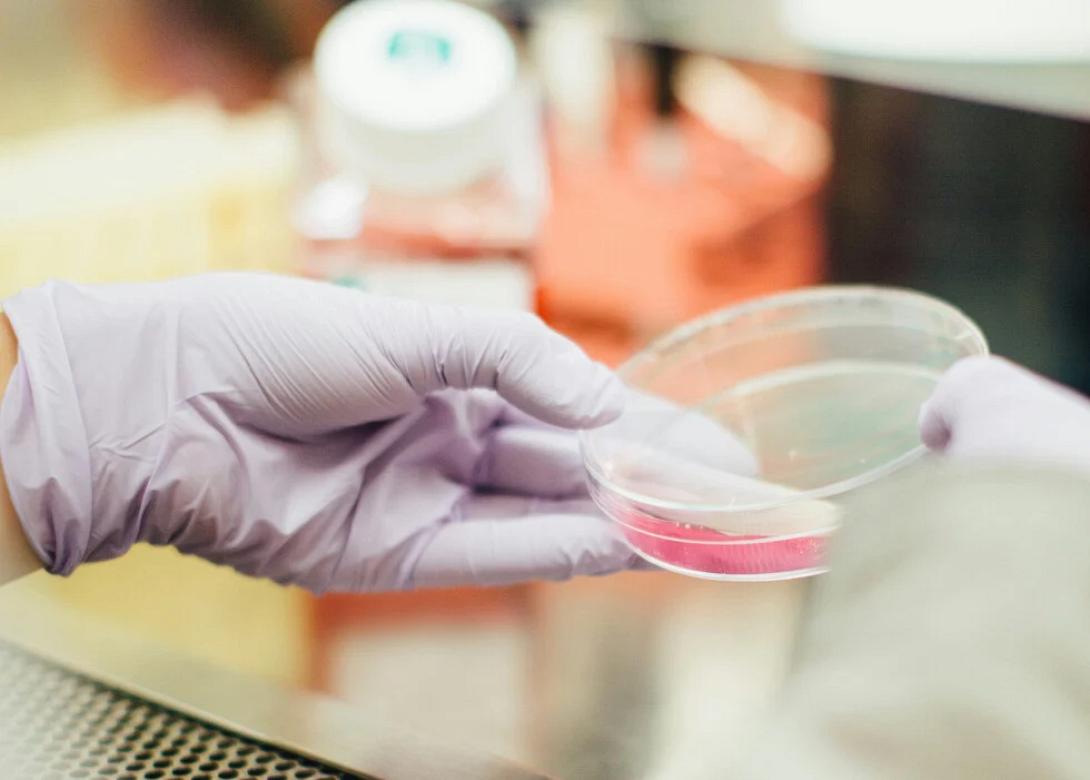
εντερο

Τα βακτήρια του εντέρου πιθανόν επηρεάζουν καρδιαγγειακές παθήσεις, σύμφωνα με νέα επιστημονική μελέτη που έγινε από ινστιτούτο του ΜΙΤ, του Harvard και του Γενικού Νοσοκομείου της Μασαχουσέτης.
Στην πρόσφατη μελέτη που δημοσιεύτηκε στο επιστημονικό περιοδικό Cell, οι ερευνητές εντόπισαν συγκεκριμένα βακτήρια που ζουν στο έντερο και «καταναλώνουν» χοληστερόλη βοηθώντας με αυτό τον τρόπο την μείωση της χοληστερόλης και του κινδύνου καρδιακών παθήσεων.
Οι ερευνητές ανακάλυψαν ότι ένας συγκεκριμένος τύπος βακτηρίων που λέγεται Oscillibacter προσλαμβάνει και μεταβολίζει τη χοληστερόλη από το περιβάλλον τους και ότι οι άνθρωποι που έφεραν υψηλότερα επίπεδα του βακτηρίου στο έντερό τους είχαν χαμηλότερα επίπεδα χοληστερόλης. Επίσης, βρήκαν ένα άλλο είδος βακτηρίων του εντέρου - Eubacterium coprostanoligenes - που επίσης συμβάλλει στη μείωση των επιπέδων της χοληστερόλης και μπορεί να έχει αλληλεπίδραση με το Oscillibacter. Τέλος, εντόπισαν και τον μηχανισμό που πιθανώς χρησιμοποιούν τα βακτήρια για να διασπάσουν τη χοληστερόλη.
Τα αποτελέσματα υποδηλώνουν ότι παρεμβάσεις που σχετίζονται με το μικροβίωμα θα μπορούσαν μια μέρα να βοηθήσουν στη μείωση της χοληστερόλης στους ανθρώπους. Επίσης, θέτουν τις βάσεις για πιο στοχευμένες έρευνες σχετικά με το πώς οι αλλαγές στο μικροβίωμα επηρεάζουν την υγεία και τις ασθένειες.
Οι αλλαγές στο μικροβίωμα του εντέρου συνδέονται επιπλέον με μια σειρά ασθενειών, όπως ο διαβήτης τύπου 2, η παχυσαρκία και η φλεγμονώδης νόσος του εντέρου. Επίσης, άλλοι ερευνητές έχουν αποκαλύψει συνδέσεις μεταξύ της σύνθεσης του μικροβιώματος του εντέρου, των τριγλυκεριδίων και των επιπέδων σακχάρου στο αίμα ενός ατόμου έπειτα από ένα γεύμα. Ωστόσο, όπως σημειώνει η ερευνητική ομάδα, δεν έχουν καταφέρει να στοχεύσουν αυτές τις συνδέσεις με θεραπείες, εν μέρει επειδή δεν έχουν πλήρη κατανόηση των μεταβολικών οδών στο έντερο.
Για την νέα μελέτη Framingham Heart Study ερευνήθηκαν μεταβολίτες και μικροβιακά γονιδιώματα από περισσότερους από 1.400 συμμετέχοντες, ενώ η διάρκεια της κράτησε δεκαετίες για την μελέτη παραγόντων κινδύνου καρδιαγγειακών νοσημάτων.
Διαβάστε επίσης
Έρπητας ζωστήρας: Εμβόλιο σχετίζεται με χαμηλότερο κίνδυνο άνοιας
Ξέχνα τη στυτική δυσλειτουργία με 5 φυσικά συστατικά που θα σε ανεβάσουν!